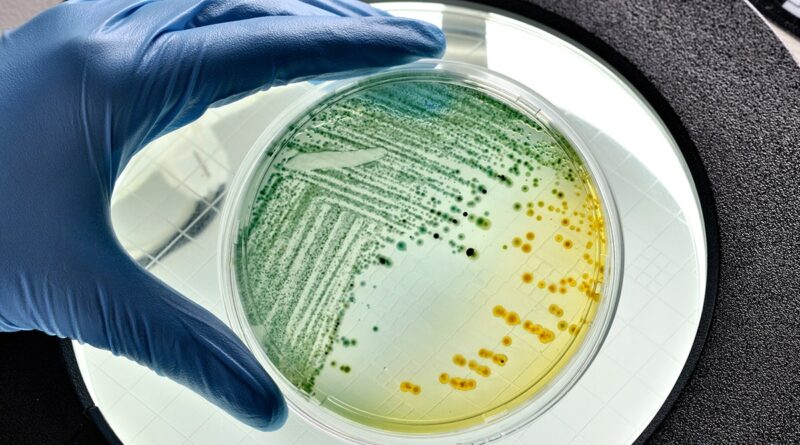

Microgravity research in space could help fight drug-resistant superbugs
NEWYou can now listen to Fox News articles!
Research conducted partly aboard the International Space Station (ISS) suggests that “microgravity” could help scientists fight drug-resistant superbugs, according to a report from SWNS.
Microgravity is the condition in which people or objects appear to be weightless, NASA states.
Experiments by researchers at the University of Wisconsin-Madison show that viruses and bacteria behave differently in near-weightless conditions. In space, they develop genetic changes not typically seen on Earth.
DEADLY ‘SUPERBUG’ IS SPREADING ACROSS US AS DRUG RESISTANCE GROWS, RESEARCHERS WARN
Lead study author Dr. Phil Huss, a researcher at the University of Wisconsin–Madison, noted that interactions between viruses that infect bacteria — known as phages — and their hosts play an “integral” role in how microbial ecosystems function, per the SWSN report.
Viruses that infect bacteria were still able to infect E. coli in space. However, the way those infections unfolded was different from what is typically observed on Earth.

E. coli is a group of bacteria that can live in the gut and are harmless most of the time, according to Cleveland Clinic. (iStock)
Bacteria and phages are often described as being locked in an evolutionary arms race, Huss said, with each side constantly adapting to outmaneuver the other.
“Microgravity is not just a slower or noisier version of Earth — it is a distinct physical and evolutionary environment,” researcher Srivatsan Raman, Ph.D., professor of biochemistry at the university, told Fox News Digital.
“Even in a very simple phage-bacteria system, microgravity altered infection dynamics and pushed both organisms down different evolutionary paths,” he added.
CONTAMINATED MEAT BLAMED FOR RISE IN COMMON URINARY INFECTIONS, EXPERTS WARN
While these interactions between bacteria and phages have been well-studied on Earth, few studies have examined them in space, where they can lead to different outcomes.
For the study, Huss and his colleagues compared two sets of E. coli samples infected with a phage known as T7. One set was incubated on Earth, while the other was grown aboard the ISS.

The ISS is a microgravity environment — where people and objects appear weightless. (NASA / SWNS)
The team found that after an initial slowdown, the T7 phage successfully infected E. coli in space. Genetic analysis later revealed clear differences in how both the bacteria and the virus mutated in space compared with how they behaved on Earth, per the report.
Huss said the phages grown aboard the space station developed mutations that could improve their ability to infect bacteria or attach to bacterial cells. At the same time, the E. coli grown in space developed mutations that could help them resist infection and survive better in near-weightless conditions.
GROWING ANTIBIOTIC CRISIS COULD TURN BACTERIAL INFECTIONS DEADLY, EXPERTS WARN
Raman said some of the findings were unexpected. In particular, he noted, microgravity led to mutations in parts of the phage genome that are not well-understood and are rarely seen in Earth-based experiments.

The E. coli grown in space developed mutations that could help them resist infection and survive better in near-weightless conditions. (iStock)
Researchers then used a technique called deep mutational scanning — a method that tracks how genetic changes affect function — to examine changes in the T7 receptor-binding protein, which plays a key role in infection.
Additional experiments on Earth linked those changes to increased effectiveness against E. coli strains that are normally resistant to T7.
CLICK HERE FOR MORE HEALTH STORIES
“Equally surprising was that phages shaped by microgravity could be more effective against terrestrial bacterial pathogens when brought back to Earth,” Raman told Fox News Digital.
“That result suggests microgravity can reveal combinations of mutations that are difficult to access through standard laboratory evolution, but [are] still highly relevant for real-world applications.”
“Microgravity is not just a slower or noisier version of Earth — it is a distinct physical and evolutionary environment.”
Huss said the findings could help address antibiotic-resistant infections, including urinary tract infections, which have been increasing in recent years.
“By studying those space-driven adaptations, we identified new biological insights that allowed us to engineer phages with far superior activity against drug-resistant pathogens back on Earth,” Huss told SWNS.
Study limitations
“Experiments on the ISS are constrained by small sample sizes, fixed hardware and scheduling constraints,” Raman noted. “Samples also experience freezing and long storage times, which can complicate interpretation.”
TEST YOURSELF WITH OUR LATEST LIFESTYLE QUIZ
He added that the research has broader implications.
“Studying microbes in space isn’t just about space biology,” Raman said. “These experiments can uncover new aspects of viral infection and microbial evolution that feed directly back into terrestrial problems, including antimicrobial resistance and phage therapy.”

Space should be treated as a discovery environment rather than a routine testing platform, one researcher said. (iStock)
He added that space should be treated as a discovery environment rather than a routine testing platform. The most effective approach, according to Raman, is to identify useful patterns and mutations in space and then study them carefully in Earth-based systems.
CLICK HERE TO SIGN UP FOR OUR HEALTH NEWSLETTER
Scientists also noted that the findings highlight how microbial ecosystems, like those associated with humans, could change during long space missions.
CLICK HERE TO DOWNLOAD THE FOX NEWS APP
“Understanding and anticipating those changes will be essential as space travel becomes longer, more routine and more biologically complex,” Raman said.
The findings were published in the journal PLOS Biology.